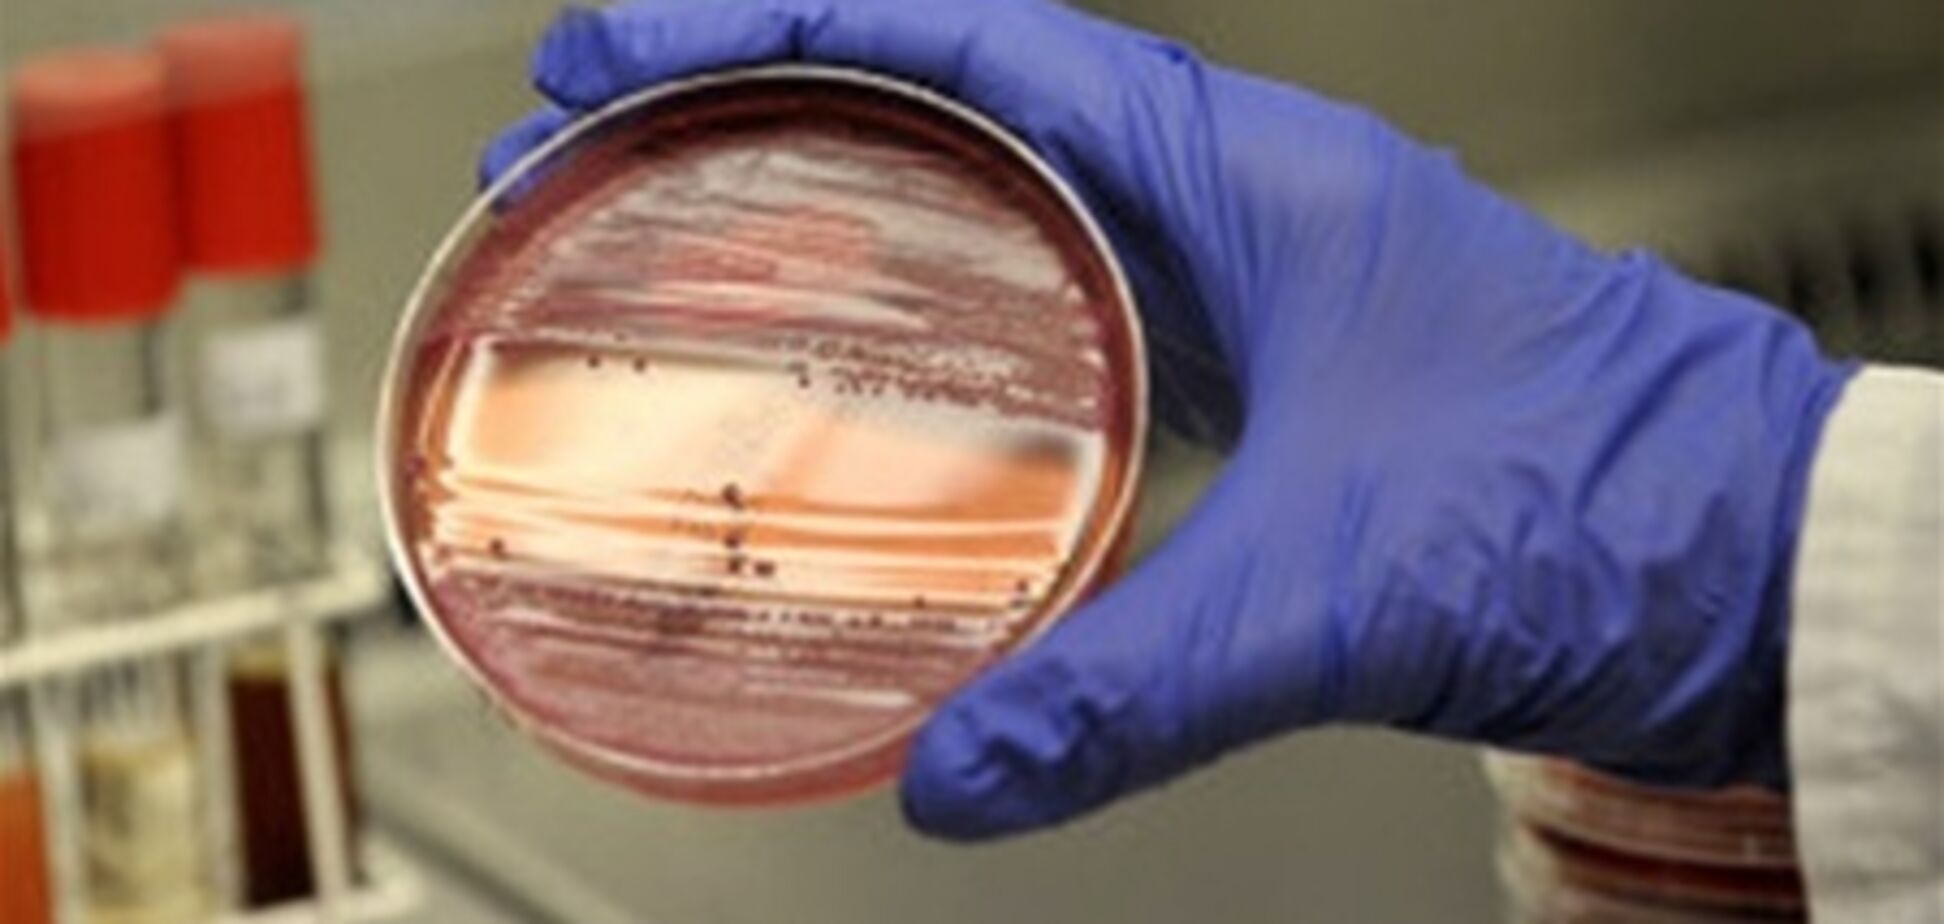
В Германии объявили о завершении эпидемии кишечной инфекции

В Германии объявили о завершении эпидемии кишечной инфекции
Виртуальный мемориал погибших борцов за украинскую независимость: почтите Героев минутой вашего внимания!
Эпидемия кишечной инфекции в Германии завершилась, говорится в сообщении Института Роберта Коха, распространенном во вторник, 26 июля.
Отмечается, что последний случай заболевания, вызванного мутировавшим штаммом кишечной палочки E.coli, был зафиксирован 4 июля. По словам президента Института Роберта Коха Райнхарда Бургера (Reinhard Burger), эпидемию можно считать завершившейся, так как о новых случаях заражения этой инфекцией с тех пор не сообщалось, а инкубационный период возбудителя болезни составляет как раз три недели.
Наблюдения за штаммом E.coli O104:H4, однако, будут продолжаться. Президент Института Коха призвал врачей проявлять особое внимание к тем пациентам, у которых обнаруживаются симптомы опасной кишечной инфекции.
Жертвами эпидемии, начавшейся в конце мая, стали 50 человек. Как сообщалось ранее, 48 из них были жителями ФРГ. Еще два человека скончались в Швеции и США; перед заболеванием они посещали Германию. Всего же был зарегистрирован 4321 случай заболевания в 16 странах.
Источник заражения долгое время найти не удавалось. Сначала причинами эпидемии назывались огурцы из Испании или ростки сои из Германии. Из-за этого многие государства запретили ввоз овощей из Европы. В итоге ВОЗ пришла к выводу, что источником заражения стали проросшие семена бобовых.










